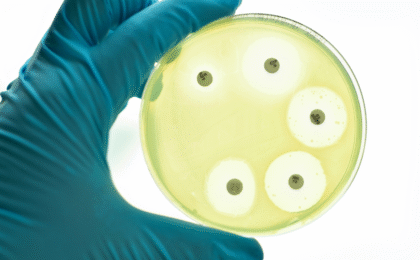

La qualité sans compétence qualité : l’erreur qui bloque les laboratoires
Lorsqu'on veut mettre en place une démarche qualité au laboratoire, on a toujours de bonnes intentions.
On commence avec une réunion, la désignation d'un responsable qualité, et les premières procédures commencent